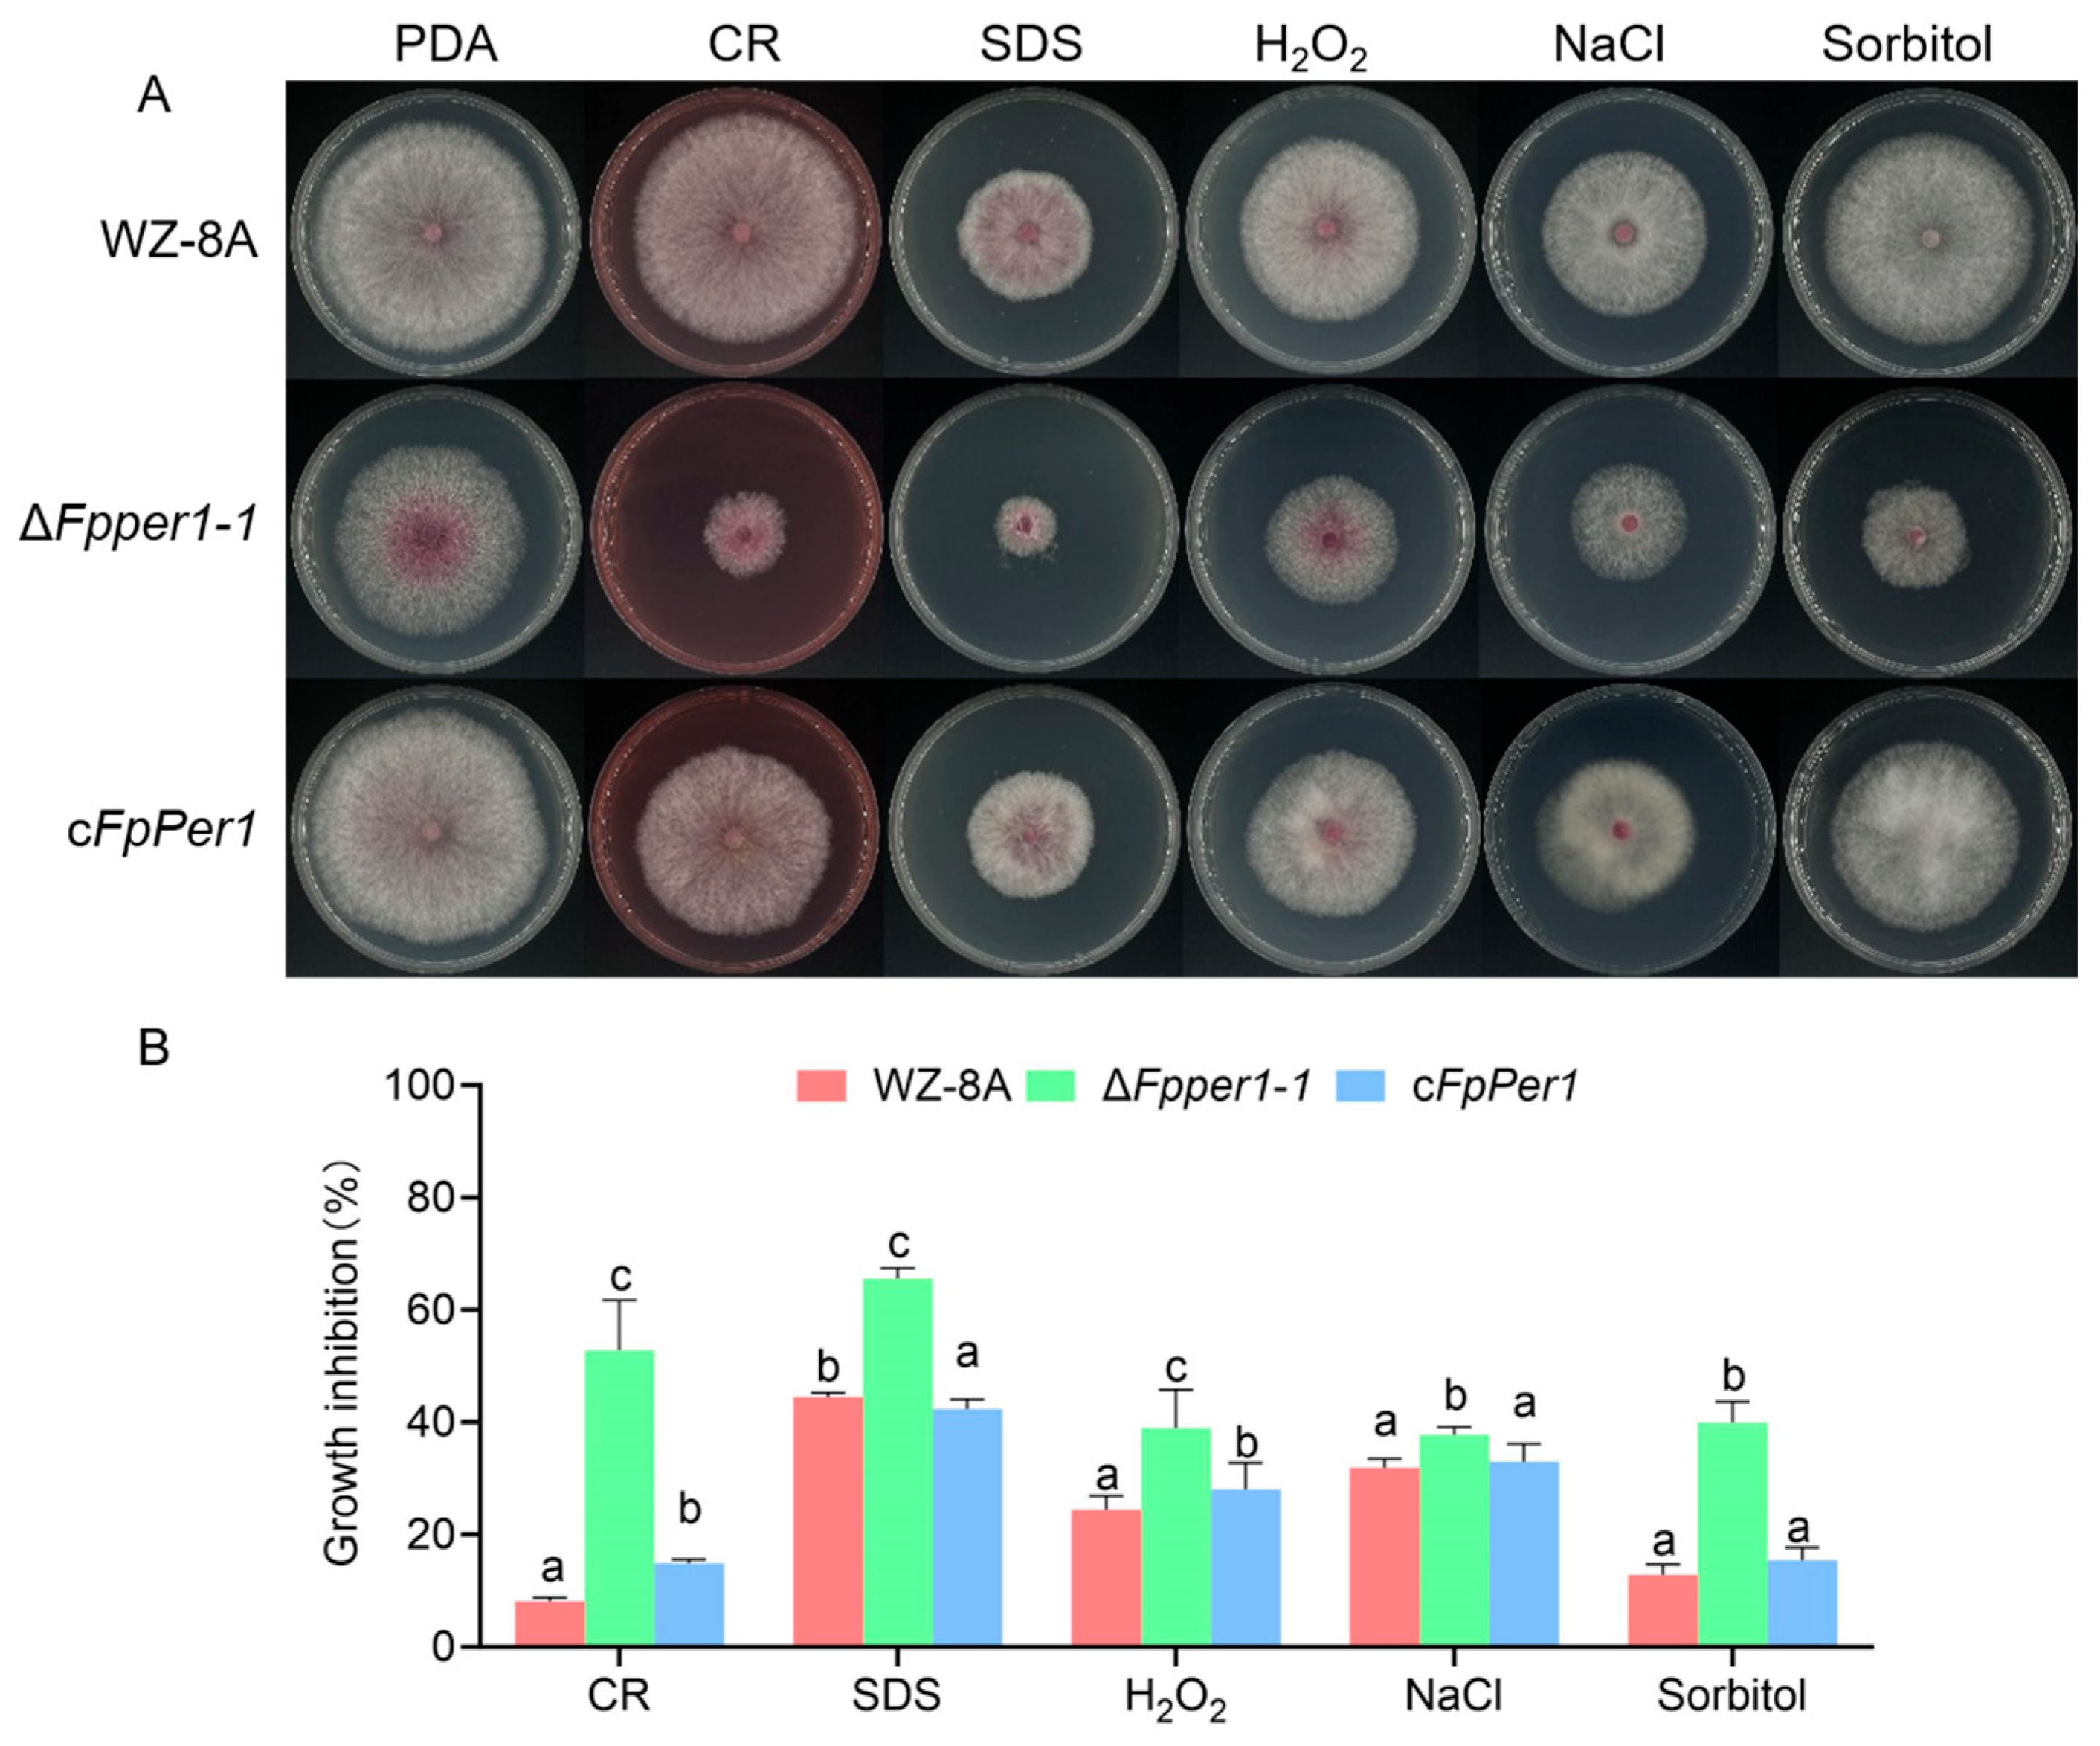

T-DNA Mutagenesis Reveals FpPer1 as a Dual-Function Regulator of Virulence and Fungicide Resistance in Fusarium pseudograminearum
Abstract
1. Introduction
2. Materials and Methods
2.1. Strain and Culture Conditions
2.2. Knockout and Complementation of the FpPER1 Gene
2.3. Biological Assays
2.4. Pathogenicity Assay
2.5. Subcellular Localization of FpPer1
2.6. Sensitivity Assays to Different Fungicides
3. Results
3.1. Identification of Tebuconazole Resistance-Related Genes by Screening Mutant Library
3.2. FpPER1 Is Involved in Growth and Conidia Production of F. pseudograminearum
3.3. Deletion Mutant ΔFpper1 Shows Increased Sensitivity to Various Stress Conditions
3.4. FpPER1 Is Essential for Full Virulence in F. pseudograminearum
3.5. FpPer1 Locates in the Endoplasmic Reticulum in F. pseudograminearum
3.6. FpPer1 Involves in Resistance to Pesticide in F. pseudograminearum
4. Discussion
Supplementary Materials
Author Contributions
Funding
Data Availability Statement
Conflicts of Interest
Correction Statement
References
- Sandiswa, F.; Khayalethu, N.; Learnmore, M.; Tarekegn, T.; Tsilo, J.T.; Hussein, S. Breeding wheat for durable leaf rust resistance in southern Africa: Variability, distribution, current control strategies, challenges and future prospects. Front. Plant Sci. 2020, 11, 549. [Google Scholar] [CrossRef]
- Zhu, Z.; Hao, Y.; Mergoum, M.; Bai, G.; Humphreys, G.; Cloutier, S.; Xia, X.; He, Z. Breeding wheat for resistance to Fusarium head blight in the Global North: China, USA, and Canada. Crop J. 2019, 7, 730–738. [Google Scholar] [CrossRef]
- Li, H.L.; Yuan, H.X.; Fu, B.; Xing, X.P.; Sun, B.J.; Tang, W.H. First report of Fusarium pseudograminearum causing crown rot of wheat in Henan, China. Plant Dis. 2012, 96, 1065. [Google Scholar] [CrossRef]
- Jin, J.; Duan, S.; Qi, Y.; Yan, S.; Li, W.; Li, B.; Xie, C.; Zhen, W.; Ma, J. Identification of a novel genomic region associated with resistance to Fusarium crown rot in wheat. Theor. Appl. Genet. 2020, 133, 2063–2073. [Google Scholar] [CrossRef] [PubMed]
- Ma, G.; Wang, H.; Qi, K.; Ma, L.; Zhang, B.; Zhang, Y.; Jiang, H.; Wu, X.; Qi, J. Isolation, characterization, and pathogenicity of Fusarium species causing crown rot of wheat. Front. Microbiol. 2024, 15, 1405115. [Google Scholar] [CrossRef] [PubMed]
- Xu, F.; Song, Y.L.; Yang, G.Q.; Wang, J.M.; Liu, L.L.; Li, Y.H. First Report of Fusarium pseudograminearum from wheat heads with Fusarium head blight in North China Plain. Plant Dis. 2015, 99, 156. [Google Scholar] [CrossRef] [PubMed]
- He, X.L.; Zhou, H.F.; Yuan, H.X.; Shi, Y.; Sun, B.J.; Li, H.L. Genetic Diversity of Fusarium pseudograminearum collected from Henan and Hebei winter wheat regions. Sci. Agric. Sin. 2016, 49, 272–281. [Google Scholar]
- Li, H.Y.; Zhang, Y.; Qin, C.C.; Wang, Z.F.; Hao, L.J.; Zhang, P.P.; Yuan, Y.Q.; Ding, C.P.; Wang, M.X.; Zan, F.F.; et al. Identification and characterization of FpRco1 in regulating vegetative growth and pathogenicity based on T-DNA insertion in Fusarium pseudograminearum. J. Integr. Agric. 2024, 23, 3055–3065. [Google Scholar] [CrossRef]
- Jiang, J.; He, K.; Wang, X.; Zhang, Y.; Guo, X.; Qian, L.; Gao, X.; Liu, S. Transcriptional dynamics of Fusarium pseudograminearum under high fungicide stress and the important role of FpZRA1 in fungal pathogenicity and DON toxin production. Int. J. Biol. Macromol. 2024, 276, 133662. [Google Scholar] [CrossRef]
- Yang, X.; Cao, S.; Sun, H.; Deng, Y.; Zhang, X.; Li, Y.; Ma, D.; Chen, H.; Li, W. The critical roles of the Zn2Cys6 transcription factor Fp487 in the development and virulence of Fusarium pseudograminearum: A potential target for Fusarium crown rot control. Microbiol. Res. 2024, 285, 127784. [Google Scholar] [CrossRef]
- Liu, Z.R.; Wang, X.L.; Wang, Z.F.; Hao, L.J.; Qin, C.C.; Zhan, F.F.; Zhang, Y.; Meng, J.X.; Li, Y.; Chen, C.; et al. FpCDP1 from Fusarium pseudograminearum is recognized as a novel pathogen-associated molecular pattern that induces plant immunity. Plant Cell Environ. 2025, 48, 5699–5709. [Google Scholar]
- Yang, Q.; Wang, J.; Sun, J.X.; Gao, S.J.; Zheng, H.; Pan, Y.M. A Fusarium pseudograminearum secreted protein Fp00392 is a major virulence factor during infection and is recognized as a PAMP. J. Integr. Agric. 2025, 2, 30. [Google Scholar]
- Zhou, Y.J.; Xu, J.Q.; Zhu, Y.Y.; Duan, Y.B.; Zhou, M.G. Mechanism of action of the benzimidazole fungicide on: Interfering with polymerization of monomeric tubulin but not polymerized microtubule. Phytopathology 2016, 106, 807–813. [Google Scholar] [CrossRef] [PubMed]
- Zhang, C.; Chen, Y.; Yin, Y.; Ji, H.H.; Shim, W.B.; Hou, Y.; Zhou, M.; Li, X.D.; Ma, Z. A small molecule species specifically inhibits Fusarium myosin I. Environ. Microbiol. 2015, 17, 2735–2746. [Google Scholar] [CrossRef]
- Ma, B.; Tredway, L.P. Induced overexpression of cytochrome P450 sterol 14α-demethylase gene (CYP51) correlates with sensitivity to demethylation inhibitors (DMIs) in Sclerotinia homoeocarpa. Pest Manag. Sci. 2013, 69, 1369–1378. [Google Scholar] [CrossRef]
- Shao, W.; Sun, J.; Zhang, X.; Chen, C. Amino acid polymorphism in succinate dehydrogenase subunit c involved in biological fitness of Botrytis cinerea. Mol. Plant Microbe Interact. 2020, 33, 580–589. [Google Scholar] [CrossRef]
- Yin, Y.; Miao, J.; Shao, W.; Liu, X.; Zhao, Y.; Ma, Z. Fungicide resistance: Progress in understanding mechanism, monitoring, and management. Phytopathology 2023, 113, 707–718. [Google Scholar] [CrossRef]
- Li, G.; Zhang, L.; Li, Y.; Li, X.; Gao, X.; Dai, T.; Miao, J.; Liu, X. Analysis of resistance risk and mechanism of the 14α-demethylation inhibitor ipconazole in Fusarium pseudograminearum. Pestic. Biochem. Physiol. 2024, 199, 105786. [Google Scholar] [CrossRef]
- Sharom, F.J.; Lehto, M. Glycosylphosphatidylinositol-anchored proteins: Structure, function, and cleavage by phosphatidylinositol-specific phospholipase C. Biochem. Cell Biol. 2002, 80, 535–549. [Google Scholar] [CrossRef]
- Fujita, M.; Umemura, M.; Yoko-o, T.; Jigami, Y. PER1 is required for GPI-phospholipase A2 activity and involved in lipid remodeling of GPI-anchored proteins. Mol. Biol. Cell 2006, 17, 5253–5264. [Google Scholar] [CrossRef]
- Hu, H.; Liu, T.G.; Xie, X.Y.; Li, F.Y.; Liu, C.Y.; Jiang, J.T.; Li, Z.G.; Chen, X.L. GPI anchoring controls cell wall integrity, immune evasion and surface localization of ChFEM1 for infection of Cochlibolus heterostrophus. J. Integr. Agric. 2024. [Google Scholar] [CrossRef]
- Zhou, F.; Li, G.L.; Li, J.B.; Zhang, S.; Liang, Y.H.; Gui, Y.J.; Li, W.G.; Liu, R.Q. Combined application of fluazinam with triazole fungicides results in synergistic activity against Fusarium Crown Rot. Plant Pathol. 2025, 74, 1560–1569. [Google Scholar] [CrossRef]
- Silva, T.S.; da Fonseca, L.F.; Yamada, J.K.; Pontes, N.D. Flutriafol and azoxystrobin: An efficient combination to control fungal leaf diseases in corn crops. Crop. Prot. 2021, 140, 105394. [Google Scholar] [CrossRef]
- Chen, Y.; Wu, X.Y.; Li, C.G.; Zeng, Y.B.; Tan, X.Q.; Zhang, D.Y.; Liu, Y. MoPer1 is required for growth, conidiogenesis, and pathogenicity in Magnaporthe oryzae. Rice 2018, 11, 64. [Google Scholar] [CrossRef] [PubMed]
- Chung, D.; Thammahong, A.; Shepardson, K.M.; Blosser, S.J.; Cramer, R.A. Endoplasmic reticulum localized PerA is required for cell wall integrity, azole drug resistance, and virulence in Aspergillus fumigatus. Mol. Microbiol. 2014, 92, 1279–1298. [Google Scholar] [CrossRef]
- Lv, Y.; Yang, H.; Wang, J.; Wei, S.; Zhai, H.; Zhang, S.; Hu, Y. Afper1 contributes to cell development and aflatoxin biosynthesis in Aspergillus flavus. Int. J. Food Microbiol. 2022, 377, 109828. [Google Scholar] [CrossRef]
- Free, S.J. Fungal cell wall organization and biosynthesis. Adv. Genet. 2013, 81, 33–82. [Google Scholar]
- Vaahtera, L.; Schulz, J.; Hamann, T. Cell wall integrity maintenance during plant development and interaction with the environment. Nat. Plants 2019, 5, 924–932. [Google Scholar] [CrossRef]
- Jiao, W.; Yu, H.; Cong, J.; Xiao, K.; Zhang, X.; Liu, J.; Zhang, Y.; Pan, H. Transcription factor SsFoxE3 activating SsAtg8 is critical for sclerotia, compound appressoria formation, and pathogenicity in Sclerotinia sclerotiorum. Mol. Plant Pathol. 2022, 23, 204–217. [Google Scholar] [CrossRef]
- Li, Y.; Wang, G.; Xu, J.R.; Jiang, C. Penetration peg formation and invasive hyphae development require stage-specific activation of MoGTI1 in Magnaporthe oryzae. Mol. Plant Microbe Interact. 2016, 29, 36–45. [Google Scholar] [CrossRef]
- Park, G.; Bruno, K.S.; Staiger, C.J.; Talbot, N.J.; Xu, J.R. Independent genetic mechanisms mediate turgor generation and penetration peg formation during plant infection in the rice blast fungus. Mol. Microbiol. 2004, 53, 1695–1707. [Google Scholar] [CrossRef]
- Pejenaute-Ochoa, M.D.; Tomas-Gallardo, L.; Ibeas, J.I.; Barrales, R.R. Row1, a member of a new family of conserved fungal proteins involved in infection, is required for appressoria functionality in Ustilago maydis. New Phytol. 2024, 243, 1101–1122. [Google Scholar] [CrossRef]
- Fujita, M.; Jigami, Y. Lipid remodeling of GPI-anchored proteins and its function. Biochim. Biophys. Acta 2008, 1780, 410–420. [Google Scholar] [CrossRef]

Disclaimer/Publisher’s Note: The statements, opinions and data contained in all publications are solely those of the individual author(s) and contributor(s) and not of MDPI and/or the editor(s). MDPI and/or the editor(s) disclaim responsibility for any injury to people or property resulting from any ideas, methods, instructions or products referred to in the content. |
© 2025 by the authors. Licensee MDPI, Basel, Switzerland. This article is an open access article distributed under the terms and conditions of the Creative Commons Attribution (CC BY) license (https://creativecommons.org/licenses/by/4.0/).
Share and Cite
Li, H.; Zhang, P.; Song, X.; Li, H.; Chen, C.; Wang, L.; Wang, Z.; Hao, L.; Li, Y.; Wang, X.; et al. T-DNA Mutagenesis Reveals FpPer1 as a Dual-Function Regulator of Virulence and Fungicide Resistance in Fusarium pseudograminearum. J. Fungi 2025, 11, 673. https://doi.org/10.3390/jof11090673
Li H, Zhang P, Song X, Li H, Chen C, Wang L, Wang Z, Hao L, Li Y, Wang X, et al. T-DNA Mutagenesis Reveals FpPer1 as a Dual-Function Regulator of Virulence and Fungicide Resistance in Fusarium pseudograminearum. Journal of Fungi. 2025; 11(9):673. https://doi.org/10.3390/jof11090673
Chicago/Turabian StyleLi, Haiyang, Panpan Zhang, Xueqian Song, Huiying Li, Cong Chen, Limin Wang, Zhifang Wang, Lingjun Hao, Yun Li, Xinlong Wang, and et al. 2025. "T-DNA Mutagenesis Reveals FpPer1 as a Dual-Function Regulator of Virulence and Fungicide Resistance in Fusarium pseudograminearum" Journal of Fungi 11, no. 9: 673. https://doi.org/10.3390/jof11090673
APA StyleLi, H., Zhang, P., Song, X., Li, H., Chen, C., Wang, L., Wang, Z., Hao, L., Li, Y., Wang, X., Kang, J., Li, H., Wang, M., & Ding, S. (2025). T-DNA Mutagenesis Reveals FpPer1 as a Dual-Function Regulator of Virulence and Fungicide Resistance in Fusarium pseudograminearum. Journal of Fungi, 11(9), 673. https://doi.org/10.3390/jof11090673

